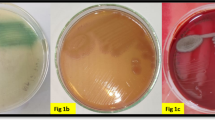

Abstract
Restriction-modification (R-M) systems protect against phage infection by detecting and degrading invading foreign DNA. However, like many prokaryotic anti-phage defences, R-M systems pose a major risk of autoimmunity, exacerbated by the presence of hundreds to thousands of potential cleavage sites in the bacterial genome. Pseudomonas aeruginosa strains experience the temporary inactivation of restriction endonucleases following growth at high temperatures, but the reason and mechanisms for this phenomenon are unknown. Here we report that P. aeruginosa type I restriction endonuclease is degraded and the methyltransferase is partially degraded, by two Lon-like proteases when replicating at >41 °C. This post-translational regulation prevents self-DNA targeting, which is a risk due to stable genomic hypomethylation, as demonstrated by single-molecule, real-time sequencing and TadA-assisted N6-methyladenosine sequencing. When cells grown at >41 °C are returned to 37 °C, full genomic methylation does not fully recover for up to 60 bacterial generations, and thus restriction activity remains off for the duration. Our findings demonstrate that type I R-M is tightly regulated post-translationally with a long memory effect that ensures genomic stability and mitigates autotoxicity.
This is a preview of subscription content, access via your institution
Access options
Access Nature and 54 other Nature Portfolio journals
Get Nature+, our best-value online-access subscription
$32.99 / 30 days
cancel any time
Subscribe to this journal
Receive 12 digital issues and online access to articles
$119.00 per year
only $9.92 per issue
Buy this article
- Purchase on SpringerLink
- Instant access to the full article PDF.
USD 39.95
Prices may be subject to local taxes which are calculated during checkout






Similar content being viewed by others
Data availability
All strains and plasmids used in this study are detailed in Supplementary Table 2 and the oligonucleotides used in this study are listed in Supplementary Table 3. The raw data from RNA-seq are available at the National Center for Biotechnology Information Gene Expression Omnibus (GEO) under accession number GSE301453. Raw data from eTAM-seq are available under GEO accession no. GSE280585. Raw data from SMRT-seq are available in the NCBI BioProject database under accession number PRJNA1293863. Proteomics data are available via ProteomeXchange with identifier PXD066156. Genomic analyses were performed using the P. aeruginosa PAO1 reference genome GCA_000006765.1. Source data are provided with this paper.
References
Doron, S. et al. Systematic discovery of antiphage defense systems in the microbial pangenome. Science 359, eaar4120 (2018).
Luria, S. E. & Human, M. L. A nonhereditary, host-induced variation of bacterial viruses. J. Bacteriol. 64, 557–569 (1952).
Millman, A. et al. An expanded arsenal of immune systems that protect bacteria from phages. Cell Host Microbe 30, 1556–1569.e5 (2022).
Georjon, H. & Bernheim, A. The highly diverse antiphage defence systems of bacteria. Nat. Rev. Microbiol. 21, 686–700 (2023).
Rocha, E. P. C. & Bikard, D. Microbial defenses against mobile genetic elements and viruses: who defends whom from what? PLoS Biol. 20, e3001514 (2022).
Tesson, F. et al. Systematic and quantitative view of the antiviral arsenal of prokaryotes. Nat. Commun. 13, 2561 (2022).
Makovets, S., Doronina, V. A. & Murray, N. E. Regulation of endonuclease activity by proteolysis prevents breakage of unmodified bacterial chromosomes by type I restriction enzymes. Proc. Natl Acad. Sci. USA 96, 9757 (1999).
Rabinkova, E. V., Torosyan, M. V. & Fradkin, G. E. Restriction alleviation of phage λ in Escherichia coli K-12 cells after γ-irradiation. Radiobiologiya 27, 563–564 (1987).
Skutel, M. et al. RecA-dependent or independent recombination of plasmid DNA generates a conflict with the host EcoKI immunity by launching restriction alleviation. Nucleic Acids Res. 1, 13–14 (2013).
Pirnay, J. P. et al. Pseudomonas aeruginosa population structure revisited. PLoS ONE 4, e7740 (2009).
Johnson, M. C. et al. Core defense hotspots within Pseudomonas aeruginosa are a consistent and rich source of anti-phage defense systems. Nucleic Acids Res. 51, 4995–5005 (2023).
Mendoza, S. D. et al. A bacteriophage nucleus-like compartment shields DNA from CRISPR nucleases. Nature 577, 244–248 (2020).
Doberenz, S. et al. Identification of a Pseudomonas aeruginosa PAO1 DNA methyltransferase, its targets, and physiological roles. mBio 8, e02312–e02316 (2017).
Roberts, R. J. et al. A nomenclature for restriction enzymes, DNA methyltransferases, homing endonucleases and their genes. Nucleic Acids Res. 31, 1805–1812 (2003).
Holloway, B. W. Variations in restriction and modification of bacteriophage following increase of growth temperature of Pseudomonas aeruginosa. Virology 26, 634–642 (1965).
O’Driscoll, J. et al. Lactococcal plasmid pNP40 encodes a novel, temperature-sensitive restriction-modification system. Appl. Environ. Microbiol. 70, 5546–5556 (2004).
Kim, J. W. et al. A novel restriction-modification system is responsible for temperature-dependent phage resistance in Listeria monocytogenes ECII. Appl. Environ. Microbiol 78, 1995–2004 (2012).
Liu, X. et al. Xenogeneic silencing relies on temperature-dependent phosphorylation of the host H-NS protein in Shewanella. Nucleic Acids Res. 49, 3427–3440 (2021).
Høyland-Kroghsbo, N. M., Muñoz, K. A. & Bassler, B. L. Temperature, by controlling growth rate, regulates CRISPR-cas activity in Pseudomonas aeruginosa. mBio 9, e02184–18 (2018).
Edwards, R. A., Allen Helm, R. & Maloy, S. R. Increasing DNA transfer efficiency by temporary inactivation of host restriction. Biotechniques 26, 892–900 (1999).
IvančicIvančic, I. et al. RecFOR function is required for DNA repair and recombination in a RecA loading-deficient recB mutant of Escherichia coli. Genetics 163, 485–494 (2003).
Murray, N. E. Type I restriction systems: sophisticated molecular machines (a legacy of Bertani and Weigle). MIicrobiol. Mol. Biol. Rev. 64, 412–434 (2000).
Bondy-Denomy, J. et al. Prophages mediate defense against phage infection through diverse mechanisms. ISME J. 10, 2854–2866 (2016).
D’Argenio, D. A., Calfee, M. W., Rainey, P. B. & Pesci, E. C. Autolysis and autoaggregation in Pseudomonas aeruginosa colony morphology mutants. J. Bacteriol. 184, 6481–6489 (2002).
Giallonardi, G. et al. Alkyl-quinolone-dependent quorum sensing controls prophage-mediated autolysis in Pseudomonas aeruginosa colony biofilms. Front. Cell Infect. Microbiol. 13, 1183681 (2023).
Xiao, Y. L. et al. Transcriptome-wide profiling and quantification of N6-methyladenosine by enzyme-assisted adenosine deamination. Nat. Biotechnol. 41, 993–1003 (2023).
Rana, M. S., Wang, X. & Banerjee, A. An improved strategy for fluorescent tagging of membrane proteins for overexpression and purification in mammalian cells. Biochemistry 57, 6741–6751 (2018).
Kindrachuk, K. N., Fernández, L., Bains, M. & Hancock, R. E. W. Involvement of an ATP-dependent protease, PA0779/AsrA, in inducing heat shock in response to tobramycin in Pseudomonas aeruginosa. Antimicrob. Agents Chemother. 55, 1874 (2011).
Breidenstein, E. B. M., Bains, M. & Hancock, R. E. W. Involvement of the Lon protease in the SOS response triggered by ciprofloxacin in Pseudomonas aeruginosa PAO1. Antimicrob. Agents Chemother. 56, 2879 (2012).
Leroux, M. & Laub, M. T. Toxin-antitoxin systems as phage defense elements. Annu. Rev. Microbiol. 76, 21–43 (2022).
Rostain, W. et al. Cas9 off-target binding to the promoter of bacterial genes leads to silencing and toxicity. Nucleic Acids Res. 51, 3485–3496 (2023).
Sauer, R. T. & Baker, T. A. AAA+ proteases: ATP-fueled machines of protein destruction. Annu. Rev. Biochem. 80, 587–612 (2011).
Mukherjee, S. et al. Adaptor-mediated Lon proteolysis restricts Bacillus subtilis hyperflagellation. Proc. Natl Acad. Sci. USA 112, 250–255 (2015).
Omnus, D. J. et al. The heat shock protein LarA activates the Lon protease in response to proteotoxic stress. Nat. Commun. 14, 7636 (2023).
Hmelo, L. R. et al. Precision-engineering the Pseudomonas aeruginosa genome with two-step allelic exchange. Nat. Protoc. 10, 1820–1841 (2015).
Shmidov, E. et al. PrrT/A, a Pseudomonas aeruginosa bacterial encoded toxin-antitoxin system Involved in prophage regulation and biofilm formation. Microbiol. Spectr. 10, e0118222 (2022).
Langmead, B. & Salzberg, S. L. Fast gapped-read alignment with Bowtie 2. Nat. Methods 9, 357–359 (2012).
Anders, S., Pyl, P. T. & Huber, W. HTSeq—a Python framework to work with high-throughput sequencing data. Bioinformatics 31, 166–169 (2015).
Love, M. I., Huber, W. & Anders, S. Moderated estimation of fold change and dispersion for RNA-seq data with DESeq2. Genome Biol. 15, 1–21 (2014).
Zhang, Y., Park, C., Bennett, C., Thornton, M. & Kim, D. Rapid and accurate alignment of nucleotide conversion sequencing reads with HISAT-3N. Genome Res. 31, 1290–1295 (2021).
Dai, Q. et al. Ultrafast bisulfite sequencing detection of 5-methylcytosine in DNA and RNA. Nat. Biotechnol. 42, 1559–1570 (2024).
Acknowledgements
This work is part of the PhD thesis of E.S. Partial funding for this work was through the Dyna and Fala Weinstock Foundation to E.B. and the President’s Scholarships and the Merit-Based Scholarships at the Institute of Nanotechnology of Bar-Ilan University to E.S. Experiments were funded by awards to J.B.D. by the Bowes Biomedical Investigator Award and the University of California, San Francisco Sanghvi-Agarwal Innovation Award research gifts. A.V. was supported by the National Science Foundation (NSF) and S.D.M. by a National Institutes of Health F31 award. We thank the Crown Genomics Institute of the Nancy and Stephen Grand Israel National Center for Personalized Medicine and the Weizmann Institute of Science for proteomics data and SMRT-seq processing and analysis support. We thank R. Lavigne for sharing the Luz24 phage. The eTAM-seq section is supported by a pilot award under grant no. RM1 HG008935. We thank Q. Dai for constructive suggestions on eTAM-seq library preparation. We thank the Single Cell Immunophenotyping Core Facility at the University of Chicago for sequencing support.
Author information
Authors and Affiliations
Contributions
E.S., A.V., S.D.M. and I.A. generated strains and conducted phenotypic experiments and analyses. E.S. drafted the initial manuscript. A.V., S.S., E.B. and J.B.-D. reviewed and edited the manuscript. Y.W. and H.Y. prepared the eTAM-seq libraries. C.Y. performed the next-generation sequencing and bioinformatics analysis, with additional analysis contributions from I.L.-L. W.T. supervised the eTAM-seq work. S.K.-L. contributed to the methodology. E.B. and J.B.-D. provided overall supervision and secured funding.
Corresponding authors
Ethics declarations
Competing interests
J.B.-D. is a scientific advisory board member of SNIPR Biome, Excision Biotherapeutics and LeapFrog Bio, consults for BiomX and is a scientific advisory board member and co-founder of Acrigen Biosciences and ePhective Therapeutics. J.B.-D.’s lab received research support from Felix Biotechnology. Patent application no. 63/417,245 has been filed for eTAM-seq by the University of Chicago. The remaining authors declare no competing interests.
Peer review
Peer review information
Nature Microbiology thanks Ajai Dandekar, Pedro Oliveira and the other, anonymous, reviewer(s) for their contribution to the peer review of this work.
Additional information
Publisher’s note Springer Nature remains neutral with regard to jurisdictional claims in published maps and institutional affiliations.
Extended data
Extended Data Fig. 1 Dynamics and conditions required for tiREN.
(a) Examination of restriction activity following overnight growth at various temperatures and sub-culture for infection with unmodified JBD30 phages at 37 °C. Values were calculated relative to the hsdR deletion strain. (b) PAO1 was grown at 43 °C for varying amounts of time. At specific time points (x-axis), CFUs/mL were measured (right y-axis) and the culture was incubated at 37 °C. Once saturated, plaque assays measured restriction activity (left y-axis).
Extended Data Fig. 2 DNA recombination and breaks do not induce tiREN.
(a) Restriction activity recombination genes mutant strains at 37 °C (blue) and following 43 °C growth, compared to WT strain. (b) Restriction activity of WT strain following 6 hr growth with sub-inhibitory concentration Fluoroquinolone treatment of Ciprofloxacin and Norfloxacin, compared to untreated WT strain. For the above graphs, restriction activity was assessed by JBD24 non-modified phages infection. For (a) and (b) graphs, the data represent the mean of three independent biological replicates +/− SD.
Extended Data Fig. 3 tiREN re-induction.
Restriction activity following overnight (ON) growth at 43 °C, 100 generations recovery at 37 °C, and re-introducing ON growth at 43 °C. Data shows a representative replicate.
Extended Data Fig. 4 HsdR expression is toxic only at tiREN state.
(a) Full plate images from spot assays of strains expressing either sfCherry (left) or hsdR (right), following ON growth at 37 °C (top) or 43 °C (bottom). (b) Growth curve at 37 °C following ON growth at either 37 °C (left) or 43 °C (right) of WT and strains harboring an inducible copy of hsdR, treated with Rha inducer. (c) Restriction activity: Infection curves were analyzed at 37 °C for WT, the hsdR mutant, and strains carrying an inducible copy of hsdR. The strains were treated with the Rha inducer, and infections were performed using un-modified JBD24 phages at an MOI of 1. (d) Activity dependence: Growth curves were conducted at 37 °C after overnight growth at 43 °C for the hsdM mutant strain carrying an inducible copy of hsdR, with or without the addition of the Rha inducer. For all the graphs above, the inducer was added at t = 0. The data represent the mean of three independent biological replicates +/− SD.
Extended Data Fig. 5 Modification hot spots at 43 °C do not specifically affect tiREN.
Restriction activity following ON growth at 37 °C (blue) or 43 °C (pink) of WT strain and mutants. Mutants are strains lacking the complete ORF containing the modification site. Restriction activity was assessed with un-modified JBD24 phages, relative to the hsdR mutant strain. The data represent the mean of three independent biological replicates +/− SD.
Extended Data Fig. 6 Restriction endonuclease is not transcriptionally regulated.
(a) Global transcriptomics analysis: Samples taken 5 generations into recovery following the 43 °C growth and at the end of the recovery phase (45 generations) were compared to normal growth conditions. Marked dots indicate Hsd proteins: HsdR and HsdMS. (b) Real-time PCR analysis of hsd transcripts following growth at either 37 °C or 43 °C. expression levels are normalized to rpoD as a ctrl. (c) Fluorescence and absorbance measurements over time of a strain harboring the hsdR ORF replaced by mCherry, representing transcriptional reporter analysis. (d) Fluorescence and optical density measurements over time of a strain harboring hsdR fused to mCherry, representing translational reporter analysis. The (c) and (d) graphs represent the mean of three independent biological replicates +/− SD.
Extended Data Fig. 7 HsdR-specific custom antibody showing a similar reduction in HsdR levels.
Endogenous measurement of Type I R-M proteins, HsdR from WT cells at 37 °C, 43 °C, or recovery at 37 °C for 10 generations by Western blot analysis using custom polyclonal antibodies, RNA pol was used as a loading ctrl.
Extended Data Fig. 8 Proteases complementation and fitness cost for restriction activation in the proteases mutant.
Protease complementation restores tiREN: (a) WT and mutant strains containing either empty vectors or plasmid-expressed protease were examined for restriction activity following ON growth at 43 °C. (b) Proteases OE at 37 °C affect restriction: Restriction activity at 37 °C with single and double proteases overexpression. Restriction activity was assessed with un-modified JBD24 phages, relative to the hsdR mutant strain. Each dot represents a single biological replicate, with error bars indicating standard deviation. (c) Flow-cytometry analysis of population variation in mixed WT and ∆hsdR strains (top), or double-proteases mutant and double mutant lacking hsdR (bottom). Mixtures were grown for six hours before analysis. Representative histograms of the reverse tagging analysis are displayed (left), and population percentages are shown as an mean of three biological replicates +/− SD. (right).
Extended Data Fig. 9 Flow cytometry gating strategy.
Shown is a representative sample: Δ2prot (GFP) vs. Δ2protΔhsdR (mCherry) at T6, 43 °C. Gating was applied sequentially as follows: (i) FSC-A vs. DAPI-A to select cells, (ii) FSC-H vs. FSC-W and SSC-H vs. SSC-W to gate singlets, (iii) FITC-A vs. PE-mCherry-A to quantify GFP-positive and mCherry-positive populations. Percentages indicate the fraction of events within each gate. The same gating strategy was used for all samples.
Supplementary information
Supplementary Table 1 (download XLSX )
The tiREN examination in different P. aeruginosa strains after growth at 43 °C, using unmodified JBD30 phages, with indicated genomic type I R-M systems.
Supplementary Table 2 (download XLSX )
Bacterial strains, phages and plasmids used in this study.
Supplementary Table 3 (download XLSX )
Oligos used in this study.
Source data
Source Data Fig. 3 (download PDF )
Unprocessed western blots.
Source Data Fig. 4 (download PDF )
Unprocessed western blots.
Source Data Fig. 5 (download PDF )
Unprocessed western blots.
Source Data Fig. 6 (download PDF )
Unprocessed western blots.
Source Data Extended Data Fig. 7 (download PDF )
Unprocessed western blots.
Rights and permissions
Springer Nature or its licensor (e.g. a society or other partner) holds exclusive rights to this article under a publishing agreement with the author(s) or other rightsholder(s); author self-archiving of the accepted manuscript version of this article is solely governed by the terms of such publishing agreement and applicable law.
About this article
Cite this article
Shmidov, E., Villani, A., Mendoza, S.D. et al. Multigenerational proteolytic inactivation of restriction upon subtle genomic hypomethylation in Pseudomonas aeruginosa. Nat Microbiol 10, 2498–2510 (2025). https://doi.org/10.1038/s41564-025-02088-3
Received:
Accepted:
Published:
Version of record:
Issue date:
DOI: https://doi.org/10.1038/s41564-025-02088-3
This article is cited by
-
Exploring the concept of bacterial memory
Nature Microbiology (2025)